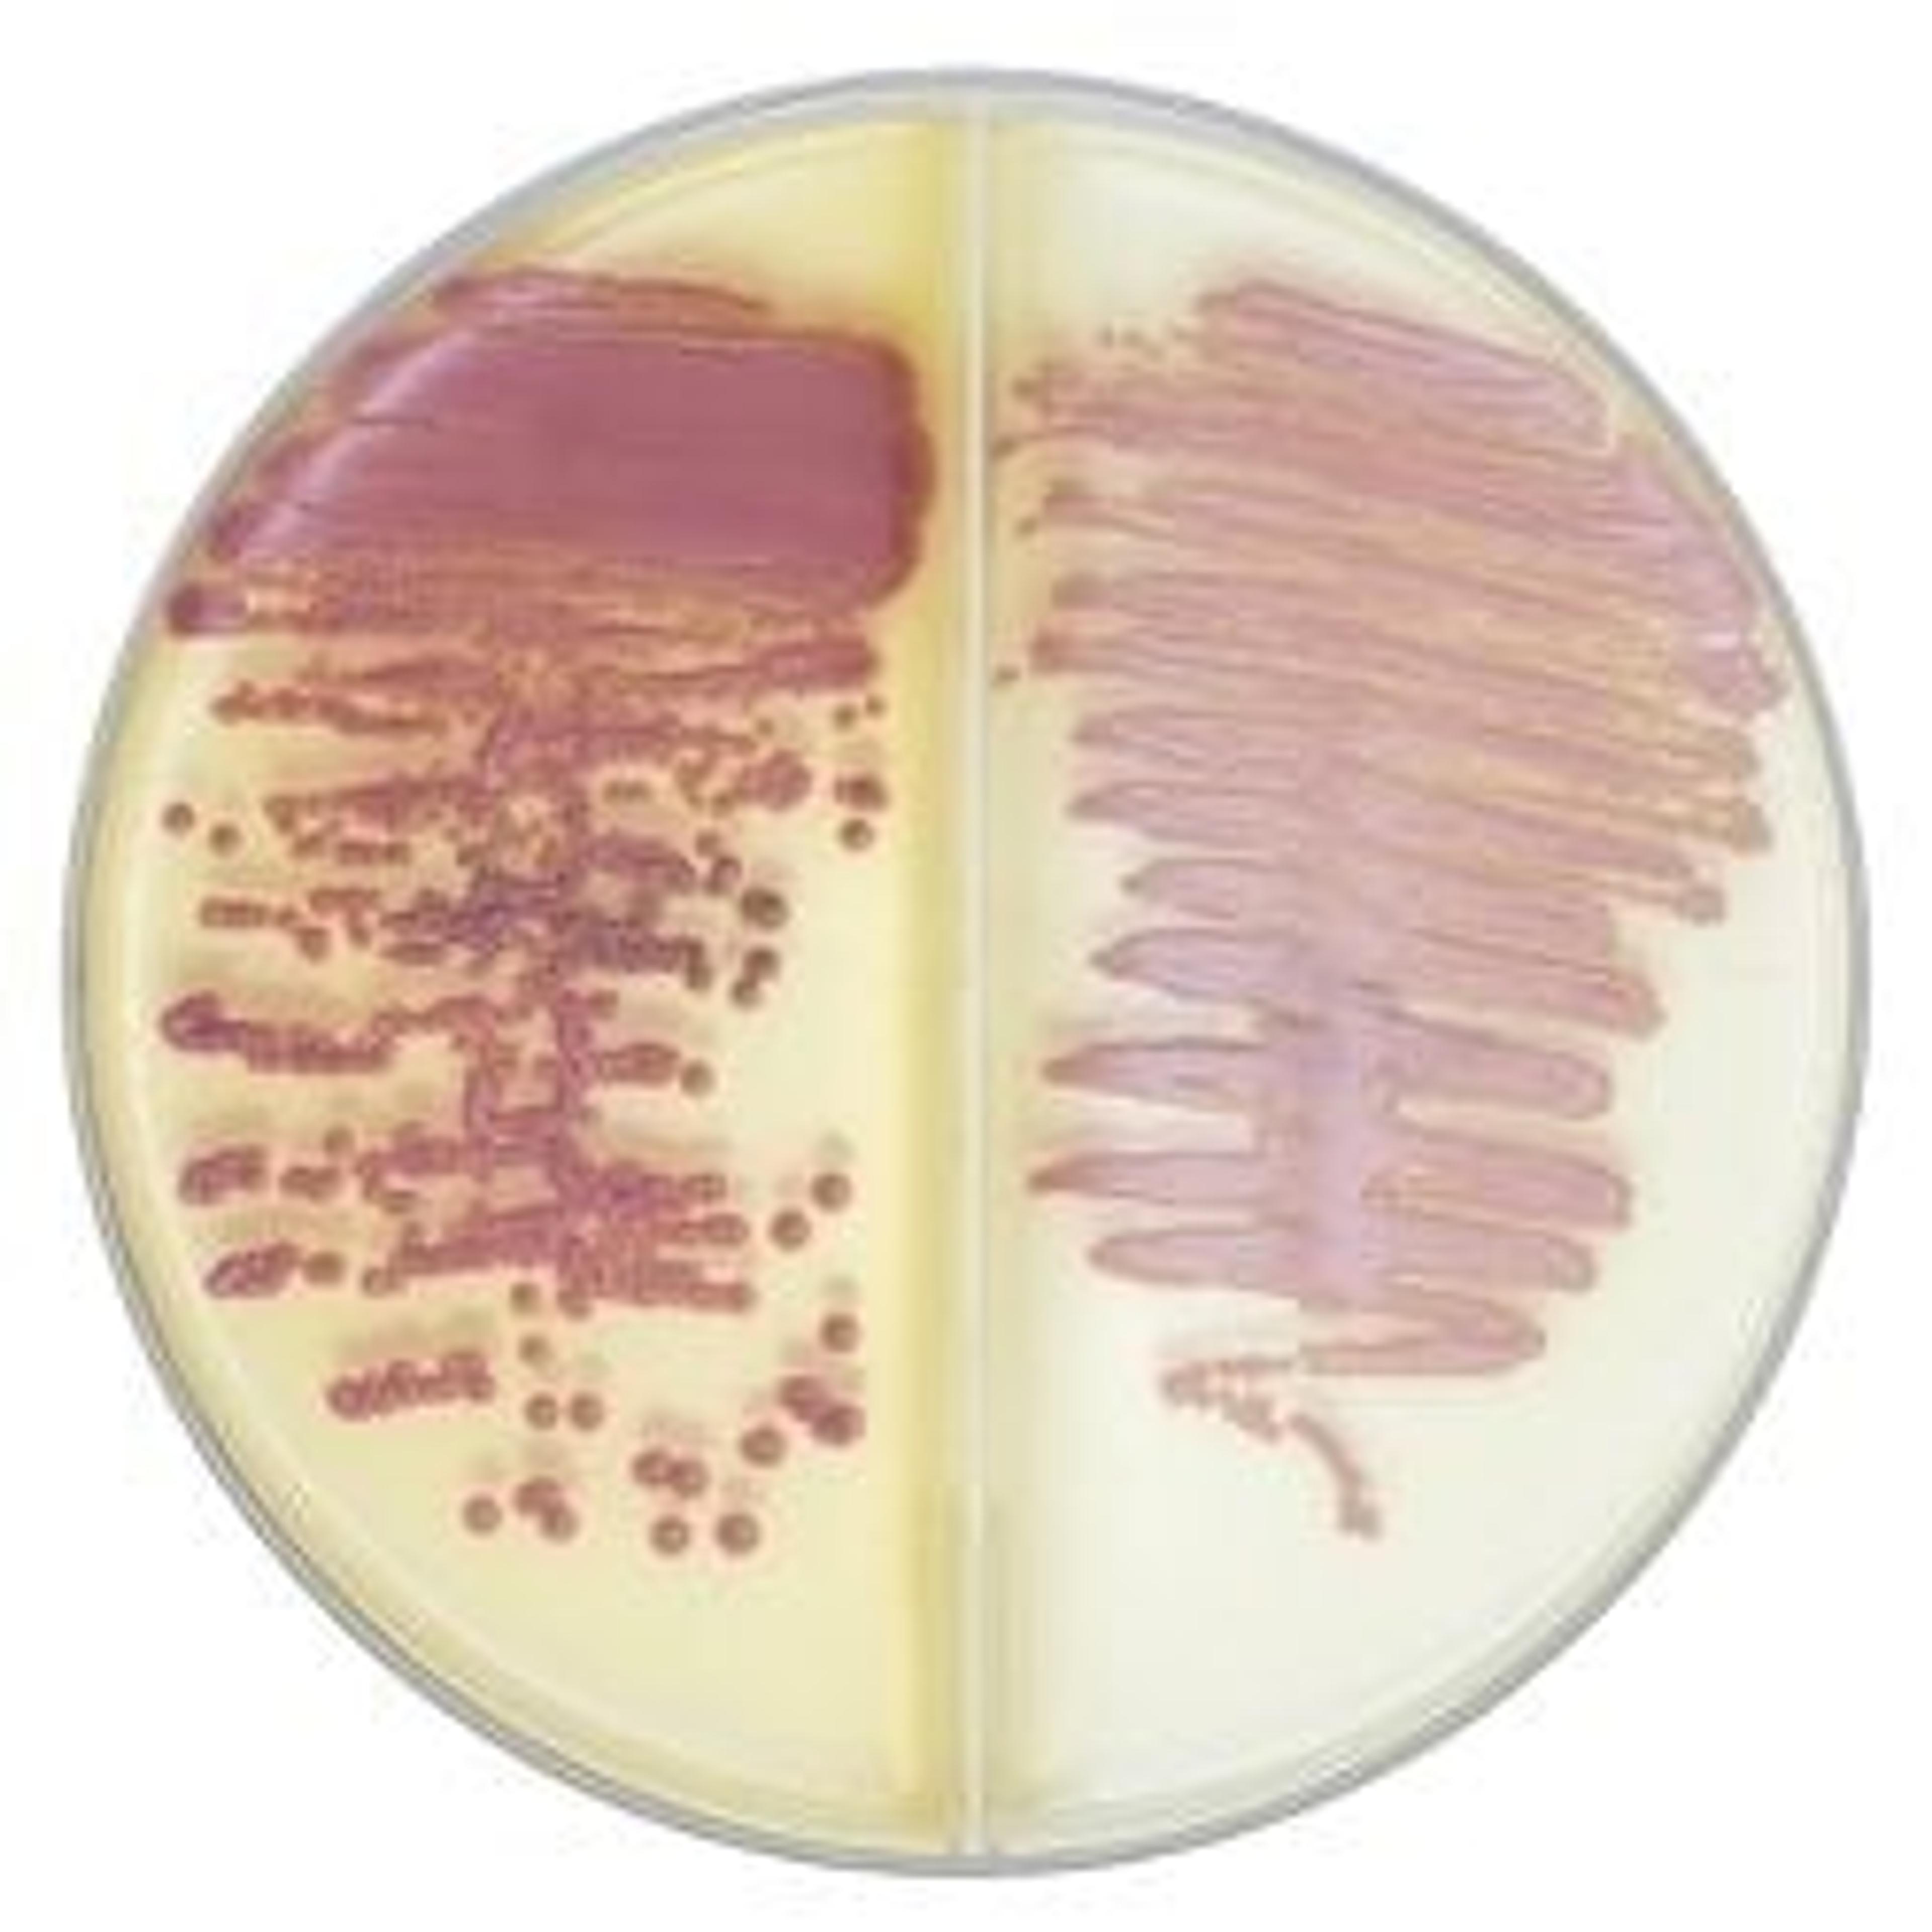
Bi-plate BD BBL™ CHROMagar™ MRSA II/CHROMagar™ Staph aureus

BD Life connected: Microbiology solutions
16 Mar 2023
BD Life Sciences presents a video introducing its company and microbiology solutions. With over 70 years of experience, BD Life Sciences has been equipping microbiologists with the necessary tools to distinguish various microbes, enabling healthcare providers to offer precise and prompt patient diagnoses. Moreover, BD Life Sciences provides a comprehensive specimen collection, and culture devices to support the identification and detection of pathogens. From specimen swabs to chromogenic medium plates, BD Integrated Diagnostic solutions are empowering clinicians and microbiologists with the necessary tools to enhance their decision-making processes.
About the company

BD Life Sciences
BD is one of the largest global medical technology companies in the world and is advancing the world of health by improving medical discovery, diagnostics and the delivery of care. The company develops innovative technology, services and solutions that help advance both clinical therapy for patients and clinical process for health care providers. BD and its 77,000 employees have a passion and commitment to help improve patient outcomes, improve the safety and efficiency of clinicians’ care delivery process, enable laboratory scientists to accurately detect disease and advance researchers’ capabilities to develop the next generation of diagnostics and therapeutics. BD has a presence in virtually every country and partners with organizations around the world to address some of the most challenging global health issues. BD helps customers enhance outcomes, lower costs, increase efficiencies, improve safety and expand access to health care. bd.com